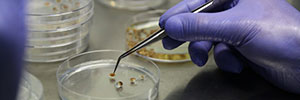

Prof. Ursula Damm
In Anlehnung an den Begriff des ‘Environment’, einen Begriff aus der künstlerischen Praxis der 1950er Jahre, in der die Diskrepanz zwischen Leben und Kunst thematisiert wurde, befasst sich die Professur der Gestaltung Medialer Umgebungen (GMU) mit Alltagssituationen, ihren Gegenständen, Apparaten und Praktiken, um diese neu zu entwerfen.
Das Konglomerat von Kultur, Technologie und Wissensproduktion fordert eine permanente Neupositionierung der Kunst in der Gesellschaft. Mit Hilfe von Experimenten hinterfragen wir unser Selbstverständnis inmitten einer sich rasant verändernden Welt. Wir begreifen unsere Zivilisation als Voraussetzung, aber auch als Herausforderung für die Suche nach neuen Strategien in der Kunst.
Unsere Handlungsräume und Kontexte sind neben Ausstellungen und Veranstaltungen: Alltagssituationen, Kooperationen mit Wissenschaften und kulturellen Partnern, das Netz und der öffentliche Raum. Es entstehen Installationen, Inszenierungen und Interventionen im Stadtraum, Wearables, Smart Objects, Performances, Visualisierungen und Simulationen, bis hin zu utopischen Stadtentwürfen. Die Gestaltung Medialer Umgebungen lädt ein zu Experimenten mit Prozessen, Schaltkreisen und Apparaten, mit anderen Lebewesen wie Einzellern, Tieren und Pflanzen. Wir kreieren Feedbacks und Kreisläufe, um aus unserer Umwelt eine Umgebung für unterschiedliche Menschen, sowie verschiedene Agenten und Spezies zu machen.